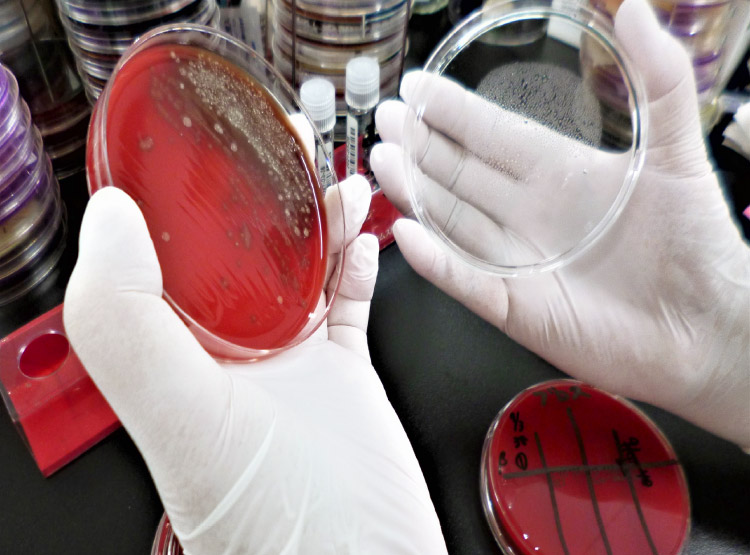

研究検査科
INDEX

検査室業務
採血室
- 当院の外来採血業務は、臨床検査技師と看護師が担っています。
- 医事課で受付後、または外来受付から渡されたファイルを持って㊵番採血室へお入りください。
- 順番にお呼びしますので、ソファーにかけてお待ちください。
- 採血ブースは隣同士に仕切り板が設けてあり、プライバシーに配慮しています。

採血室は㊵番です。

ファイルを持ったまま中でお待ちください。
血液検査
血液検査では主に以下の検査を行っています。
- 血球算定・血液像検査
- 凝固機能検査(凝固因子や活性値の測定)
- 血液ガス分析
- 骨髄検査
- 輸血検査(血液型・輸血に関わる適合検査)
生化学検査
生化学検査では主に以下の検査を行っています。
- 血液や尿の生化学項目の測定
- 感染症検査(肝炎ウイルス・梅毒・HIV・インフルエンザウイルス・SARS-CoV-2など)
- 腫瘍マーカー検査
- 血中薬物濃度検査
- 内分泌検査

一般検査
一般検査では主に以下の検査を行っています。
- 一般検尿(蛋白・糖・潜血・pH・白血球・細菌など)
- 尿沈渣(尿中の有形成分を顕微鏡で検査)
- 便潜血(便中ヘモグロビン)
微生物検査
細菌検査では主に以下の検査を行っています。
- 一般細菌や抗酸菌の培養・同定・感受性検査
- 迅速抗原定性検査(インフルエンザウイルス・SARS-CoV-2・A群溶連菌・マイコプラズマなど)
- 遺伝子検査(抗酸菌・インフルエンザウイルス・SARS-CoV-2・RSウイルス・アデノウイルスなど)
細菌培養検査

PCR検査の様子
細菌が原因と考えられる病気の場合、患者さんから採取された検体(血液・喀痰・尿など)を用いて起因していると思われる細菌を調べます。
細菌名が特定されたら、次にどの薬剤が有効かを調べていきます。
また、細菌やウイルスの特異的な遺伝子を増幅させて、迅速かつ高感度に検出する検査も行っています。
細菌名が特定されたら、次にどの薬剤が有効かを調べていきます。
また、細菌やウイルスの特異的な遺伝子を増幅させて、迅速かつ高感度に検出する検査も行っています。
生理機能検査
生理機能検査では主に以下の検査を行っています。
- 循環機能検査(心電図検査・ホルター心電図など)
- 呼吸機能検査(肺機能検査・簡易および精密終夜睡眠ポリグラフィーなど)
- 神経・筋機能検査(脳波検査・神経伝導速度検査など)
- 超音波検査(心臓・頸動脈・下肢静脈・腹部※・甲状腺※)
- その他(血管伸展性検査・聴力検査)
※診療科医師にて施行

重症でベッドから動けない患者さんや緊急を要する患者さんには、検査装置をベッドサイドまで運んで速やかに対応しています。(心電図・超音波など)
検査を受ける前に気を付けていただきたいこと
採血について
- 診察前採血が予定されている患者さんは、予約時間の30分~1時間前に来院してください。
- 食事の影響を避けるため前日の食事は早めに済ませ、当日は空腹での来院をお勧めします。
なお事前に医師の指示があれば、服薬や食事は指示に従ってください。 - 都合により、採血までお待ちいただく場合がありますが、ご了承ください。
生理機能検査について
- 検査によっては事前の飲食が制限される場合がありますのでご確認ください。
- 脳波検査や精密終夜睡眠ポリグラフィーは、頭に検査のための電極を装着するため、洗髪を済ませてきてください。
- ホルター心電図の電極装着中ではシャワーは支障ありませんが、入浴は控えてください。
